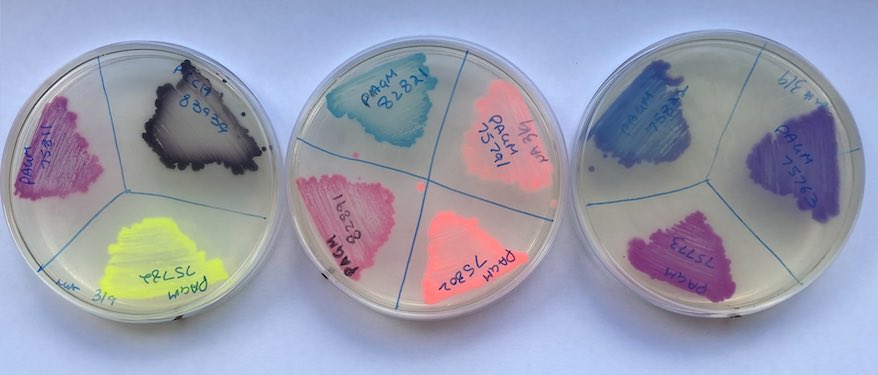
I hope it’s a fun demonstration of the diverse modules made available by our amazing Synbio team 🤩

Markus Draeger
@draegermarkus
PhD student working on growth🌱-defense🛡 signalling in Arabidopsis @TheSainsburyLab
ID: 1179703262443982850
03-10-2019 10:22:42
538 Tweet
762 Followers
1,1K Following







New pre-print from our group showing remarkable synchrony of proliferative growth & regulated cell death during plant infection-each conidial cell has different developmental fate-by the rice blast fungus EseolaAlice Xia Yan @osesmir Lauren Ryder Dan MacLean Martin Egan

This year Dr. Wenbo Ma is opening our Annual Science Meeting, one of the highlights of our scientific year! Find out more about what the Ma lab specialises in: tsl.ac.uk/our-work/scien… John Innes Centre



Huge congratulations to PhD students Lena Knorr, from Dr. Wenbo Ma's group, and AmirAli Toghani, from the Sophien Kamoun, for their 2025 ASM poster awards! 🎉🌱


Save the Date: #PPATH2026, Norwich, 8–10 September 2026 British Society for Plant Pathology



Excited to visit IHSM La Mayora this Friday. Looking forward to meeting everyone there!

Today we had the pleasure of having Neftaly Cruz Mireles Neftaly Cruz Mireles (Zurich Univ.) as part of #IHSMLaMayoraSeminars series. Neftaly shared with us his latest results on rice blast disease, which threatens Valencia’s rice fields. Thanks Neftaly!





Spooky season has arrived! 👻 We held our annual Pumpkin Carving Competition at The Sainsbury Laboratory—vote for your favourite carve! 🎃🕯️


🏆NEWS: Delighted to spot two of our group leaders on the 2025 Highly Cited Researchers list by Clarivate for Academia & Government The list aims to recognise the most influential researchers on a global scale, representing those in the top 1% by citations for their field. #HighlyCited2025